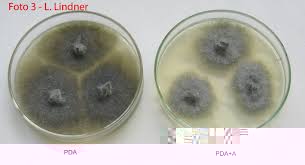
Botryosphaeria sp..jpg Botryosphaeria sp..jpg

In tal caso si tratta verosimilmente di funghi a comportamento saprofitario/parassitario (solitamente si insinuano nel periodo della fioritura all'interno del frutto in formazione e, se le condizioni ambientali sono favorevoli, si sviluppano provocando il maricume).
Circa la individuazione dell'agente responsabile talora ci si può orientare valutando il tipo di marciume (secco, molle), il suo colore (bianco, nero) e la sua progressione che a volte assume un aspetto caratteristico (si spaccano un po' di mele, che a occhio attento paiono attaccate, per vedere l'interno), ma solitamente la diagnosi avviene in laboratorio con isolamento su piastra ed esame microscopico delle spore (foto 1: aspetto su terreno di coltura
Botryospheria =
Spaeropsis sp., agente del c.d. 'marciume nero' delle mele; foto 2: aspetto macroscopico su frutto).
La difesa è di tipo preventivo e consiste nell'eliminazione di tutti quei materiali su cui possono conservare propaguli del fungo e che quindi rappresentano la fonte di inoculo (mela marce cadute a terra o mummificate sull'albero, residui di potatura etc.), e gestione dei cancri (ad es. il fungo citato provoca anche lesioni cancerose rameali).
Prova ad aprire altre mele e in particolare a controllare, come ti avevo già chiesto, se il marciume si localizza prevalentemente nella zona del peduncolo e se la parte carpellare dove ci sono i semi è più o meno indenne.
Ciao al prox giro
- Allegati
-
- Botryosphaeria sp..jpg (5.35 KiB) Osservato 1713 volte
-
